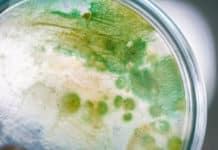
Estuarine Bacteria Eat Centuries Old Food – Metabolism Found To Be 1 Million Times Slower Estuarine Bacteria Metabolism 1 Million Times Slower - Eat Centuries Old Food

Wildlife Institute of India Project Recruitment, Life Sciences Apply
WII Life Sciences Project Jobs, Applications Invited
MSc Wildlife Science/ Botany/ Zoology/ Forestry/ Life Sciences/ Environmental Sciences/ Biological Sciences project jobs at Wildlife Institute of...
ICMR Project Research Scientist Non-Medical Post For Life Sciences
ICMR Project Research Scientist Non-Medical Post For Life Sciences
ICMR Project Research Scientist Non-Medical Post For Life Sciences. MSc & PhD Life Science, Project Research...
BIRAC Funded Biotech & Biochem Project Job at CSIR-NCL
CSIR-NCL Pune Project Jobs For Biotech & Biochem
CSIR-NCL Pune Project Jobs For Biotech & Biochem. NCL Pune is hiring PhD Degree in Biotechnology, Biochemistry...
Chittaranjan National Cancer Institute Research Associate Recruitment
CNCI Research Associate Job For Biological Sciences
CNCI Research Associate Job For Biological Sciences. PhD Biological Sciences/ Biochemistry/ Molecular Biology/ Biotechnology Research Associate job at...
Biotecnika Times Newsletter 28.12.2021 UPSC Recruitment, Breaking CSIR NET June 2021
Biotecnika Times - UPSC Recruitment, Breaking CSIR NET June 2021
🤩 Breaking CSIR NET June 2021 News – Dates Rescheduled + CSIR NET June, December...
Govt of India, MSME Khadi and Village Industries Commission Biology Recruitment
MSME Khadi and Village Industries Commission Biology Recruitment
MSME Khadi and Village Industries Commission Biology Recruitment. MSc Biology young professional job openings at Khadi and...
Biological Sciences Tata Medical Centre, Kolkata Research Assistant Recruitment
Biological Sciences Tata Medical Centre, Kolkata Research Assistant
Biological Sciences Tata Medical Centre, Kolkata Research Assistant. Tata Translational Cancer Research Center Recruitment. MSc Biological Sciences...
CSIR-IMTECH Applications On Proteins Project Recruitment, Apply Online
IMTECH Vacancy Available - Online Application Process
IMTECH Vacancy Available - Online Application Process. Project Associate-I Recruitment. MSc Natural Sciences Job. Interested and eligible applicants...
Life Sciences JRF Vacancies Available at IIT Kanpur, Applications Invited
Life Sciences JRF Vacancies Available at IIT Kanpur, Applications Invited
Life Sciences JRF Vacancies Available at IIT Kanpur, Applications Invited. MSc Life Science Job at...
Associate Safety Medical Writer Life Sciences at Novo Nordisk
Associate Safety Medical Writer Life Sciences at Novo Nordisk
Associate Safety Medical Writer Life Sciences at Novo Nordisk. MSc Life Sciences Jobs. Life Sciences Associate...
ACTREC Walk-In-Interview For SRF Post – Life Sciences Eligible
ACTREC SRF Post Recruitment - Life Sciences Eligible
ACTREC SRF Post Recruitment - Life Sciences Eligible. MSc Life Science can apply for a Senior Research...
Altem Technologies Inside Sales Life Sciences Division Recruitment
Altem Technologies Inside Sales Life Sciences Division Recruitment
Altem Technologies (P) Ltd is a leading Product Lifecycle Management (PLM) Software Partner for Dassault Systèmes and...
Breaking CSIR NET June 2021 News – Dates Rescheduled + CSIR NET June, December...
Breaking CSIR NET June 2021 News - Dates Rescheduled + CSIR NET June, December Update
Hello, and Good afternoon, welcome to Biotecnika.
We have some good...
DST Funded MSc & MTech Life Sciences JRF Recruitment at NII
NII Research Fellow Project Vacancy For Life Sciences
NII Research Fellow Project Vacancy For Life Sciences. Recruitment of MSc & MTech Life Sciences candidates at...
Important CSIR Update! Rescheduled Exam Dates for Joint CSIR-UGC NET Examination June-2021
CSIR-NET June 2021 Dates Rescheduled - Rescheduling of Exam Dates
Hello Biotecnikans,
As we all know, there was a concern raised over the CSIR NET June...